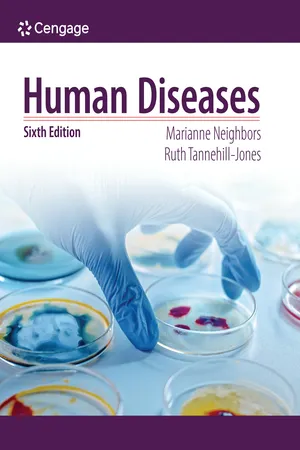
Human Diseases

- 609 pages
- English
- PDF
- Available on iOS & Android
Human Diseases
About this book
Designed specifically for future allied health professionals, HUMAN DISEASES, Sixth Edition, includes everything you need to know about the diseases and disorders health care providers see and treat most often. Making pathology fully accessible, this best-selling text is packed with the most current research available and reflects the latest practices from the field. Following a basic review of anatomy and physiology, chapters present each disease's description, etiology, symptoms, diagnosis, treatment and prevention, while detailed, full-color photos make it easier to gain a thorough understanding of key concepts. Completely up to date, the Sixth Edition includes information on new and emerging disorders, ICD-10 progress, pharmacology concerns, herbal and nontraditional remedies, current research and statistics and more. In addition, real-life cases and interactive learning tools give you hands-on experience to help you put what you learn into practice.
Tools to learn more effectively

Saving Books

Keyword Search

Annotating Text

Listen to it instead
Information
Table of contents
- Cover
- Title Page
- Contents
- List of Tables
- Preface
- Reviewers
- UNIT 1: CONCEPTS OF HUMAN DISEASE
- UNIT II: COMMON DISEASES AND DISORDERS OF BODY SYSTEMS
- UNIT III: GENETIC AND DEVELOPMENTAL, CHILDHOOD, AND MENTAL HEALTH DISEASES AND DISORDERS
- Appendix A: References
- Appendix B: Common Laboratory Values
- Appendix C: Metric Conversion Tables
- Glossary
- Index
Frequently asked questions
- Essential is ideal for learners and professionals who enjoy exploring a wide range of subjects. Access the Essential Library with 800,000+ trusted titles and best-sellers across business, personal growth, and the humanities. Includes unlimited reading time and Standard Read Aloud voice.
- Complete: Perfect for advanced learners and researchers needing full, unrestricted access. Unlock 1.4M+ books across hundreds of subjects, including academic and specialized titles. The Complete Plan also includes advanced features like Premium Read Aloud and Research Assistant.
Please note we cannot support devices running on iOS 13 and Android 7 or earlier. Learn more about using the app